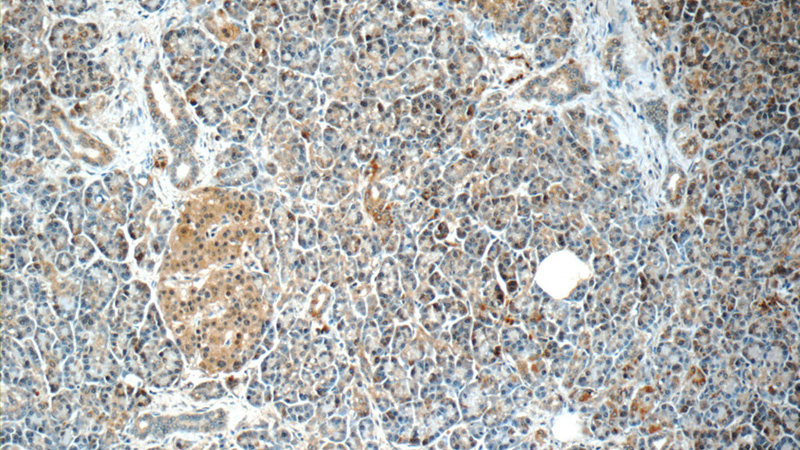
Immunohistochemistry of paraffin-embedded human pancreas slide using Catalog No:107965(ALDH1L2 Antibody) at dilution of 1:50
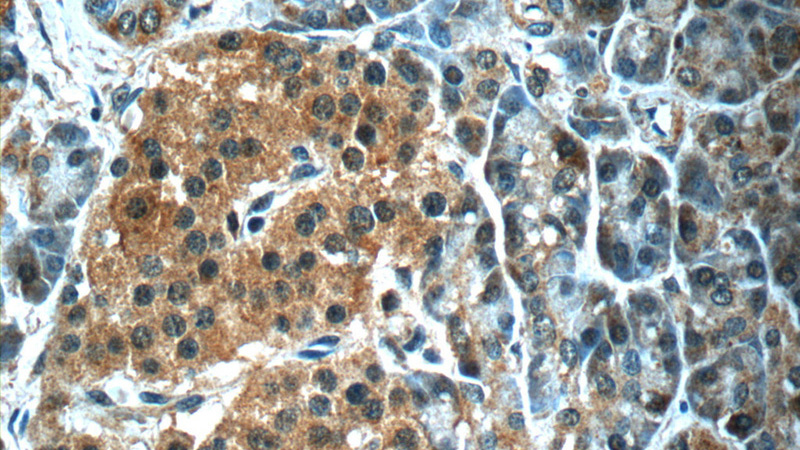
Immunohistochemistry of paraffin-embedded human pancreas slide using Catalog No:107965(ALDH1L2 Antibody) at dilution of 1:50

-
Product Name
ALDH1L2 antibody
- Documents
-
Description
ALDH1L2 Rabbit Polyclonal antibody. Positive IHC detected in human pancreas tissue, human heart tissue. Positive WB detected in mouse kidney tissue, HEK-293 cells. Observed molecular weight by Western-blot: 102 kDa, 89 kDa
-
Tested applications
ELISA, WB, IHC
-
Species reactivity
Human, Mouse; other species not tested.
-
Alternative names
ALDH1L2 antibody; DKFZp686A16126 antibody; DKFZp686M064 antibody; FLJ38508 antibody
-
Isotype
Rabbit IgG
-
Preparation
This antibody was obtained by immunization of ALDH1L2 recombinant protein (Accession Number: BC103935). Purification method: Antigen Affinity purified.
-
Clonality
Polyclonal
-
Formulation
PBS with 0.02% sodium azide and 50% glycerol pH 7.3.
-
Storage instructions
Store at -20℃. DO NOT ALIQUOT
-
Applications
Recommended Dilution:
WB: 1:200-1:2000
IHC: 1:20-1:200
-
Validations

mouse kidney tissue were subjected to SDS PAGE followed by western blot with Catalog No:107965(ALDH1L2 antibody) at dilution of 1:1000
Immunohistochemistry of paraffin-embedded human pancreas slide using Catalog No:107965(ALDH1L2 Antibody) at dilution of 1:50
Immunohistochemistry of paraffin-embedded human pancreas slide using Catalog No:107965(ALDH1L2 Antibody) at dilution of 1:50
-
Background
ALDH1L2(Aldehyde dehydrogenase family 1 member L2) is also named as mitochondrial 10-FTHFDH, mtFDH and belongs to the aldehyde dehydrogenase family and ALDH1L subfamily. The ALDH1L2 gene has three transcriptional variants with the molecular weight of 102 kDa, 42 kDa and 89 kDa(PMID:19823103). It is a mitochondrial enzyme, a likely source of CO2 production from 10-formyltetrahydrofolate in mitochondria and playing an essential role in the distribution of one-carbon groups between the cytosolic and mitochondrial compartments of the cell(PMID: 20498374). It also has dehydrogenase/hydrolase activities similar to cytosolic FDH (ALDH1L1). The native ALDH1L2 has been reported to exist as a dimer or tetramer(PMID:7822273).
Related Products / Services
Please note: All products are "FOR RESEARCH USE ONLY AND ARE NOT INTENDED FOR DIAGNOSTIC OR THERAPEUTIC USE"
